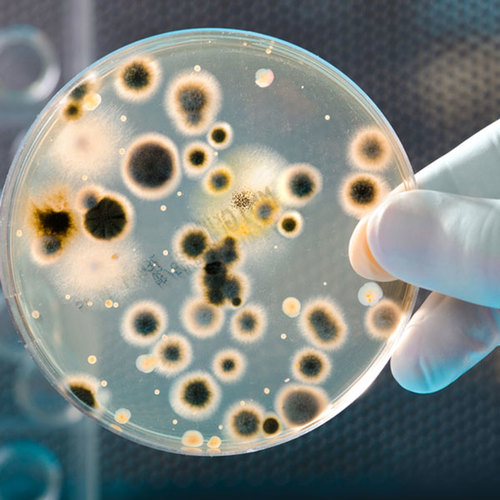
Bacteria

CALL TODAY 1-800-441-6281
CALL TODAY 1-800-441-6281

- ABOUT
- WELL DRILLING
- WELL SERVICE
-
WATER TREATMENT
- ABOUT WATER TREATMENT
- WATER TESTING
-
WATER CONTAMINATION
- Arsenic Contamination and Treatment
- Per- and Polyfluorinated Substances (PFAS)
- Radon Contamination and Treatment
- Iron & Manganese Contamination and Treatment
- Hydrogen Sulfide Contamination and Treatment
- Well Water Treatment for Sand and Sediment
- Treatment for Hard Water Contamination
- Water Treatment for Corrosivity
- $
- CONTACT
- EMPLOYMENT
- LEARN MORE
- ABOUT
- WELL DRILLING
- WELL SERVICE
-
WATER TREATMENT
- ABOUT WATER TREATMENT
- WATER TESTING
-
WATER CONTAMINATION
- Arsenic Contamination and Treatment
- Per- and Polyfluorinated Substances (PFAS)
- Radon Contamination and Treatment
- Iron & Manganese Contamination and Treatment
- Hydrogen Sulfide Contamination and Treatment
- Well Water Treatment for Sand and Sediment
- Treatment for Hard Water Contamination
- Water Treatment for Corrosivity
- $
- CONTACT
- EMPLOYMENT
- LEARN MORE
THE SKILLINGS BLOG
The knowledge center for well drilling, water treatment & testing, FAQs, tips and know-how.
water treatment
Skillings & Sons water well treatment services for clean water in NH and MA bad tasting water, bad smelling water, brown water
-
-
05/24/2012
Ground water supplies can become contaminated with bacteria after flooding. State agencies may declare a boil water advisory to ensure the public is protected from ingesting harmful pathogens.
-
-
-
Water well treatment and maintenance services, including water filtration systems, filters, water softeners and water purifiers at your home or business keep the water you drink, bathe or cook with clean, safe, and healthy. When treating city or well water in NH and MA, the goal at Skillings & Sons is to eliminate odors, staining, sediment or potentially harmful contaminants.